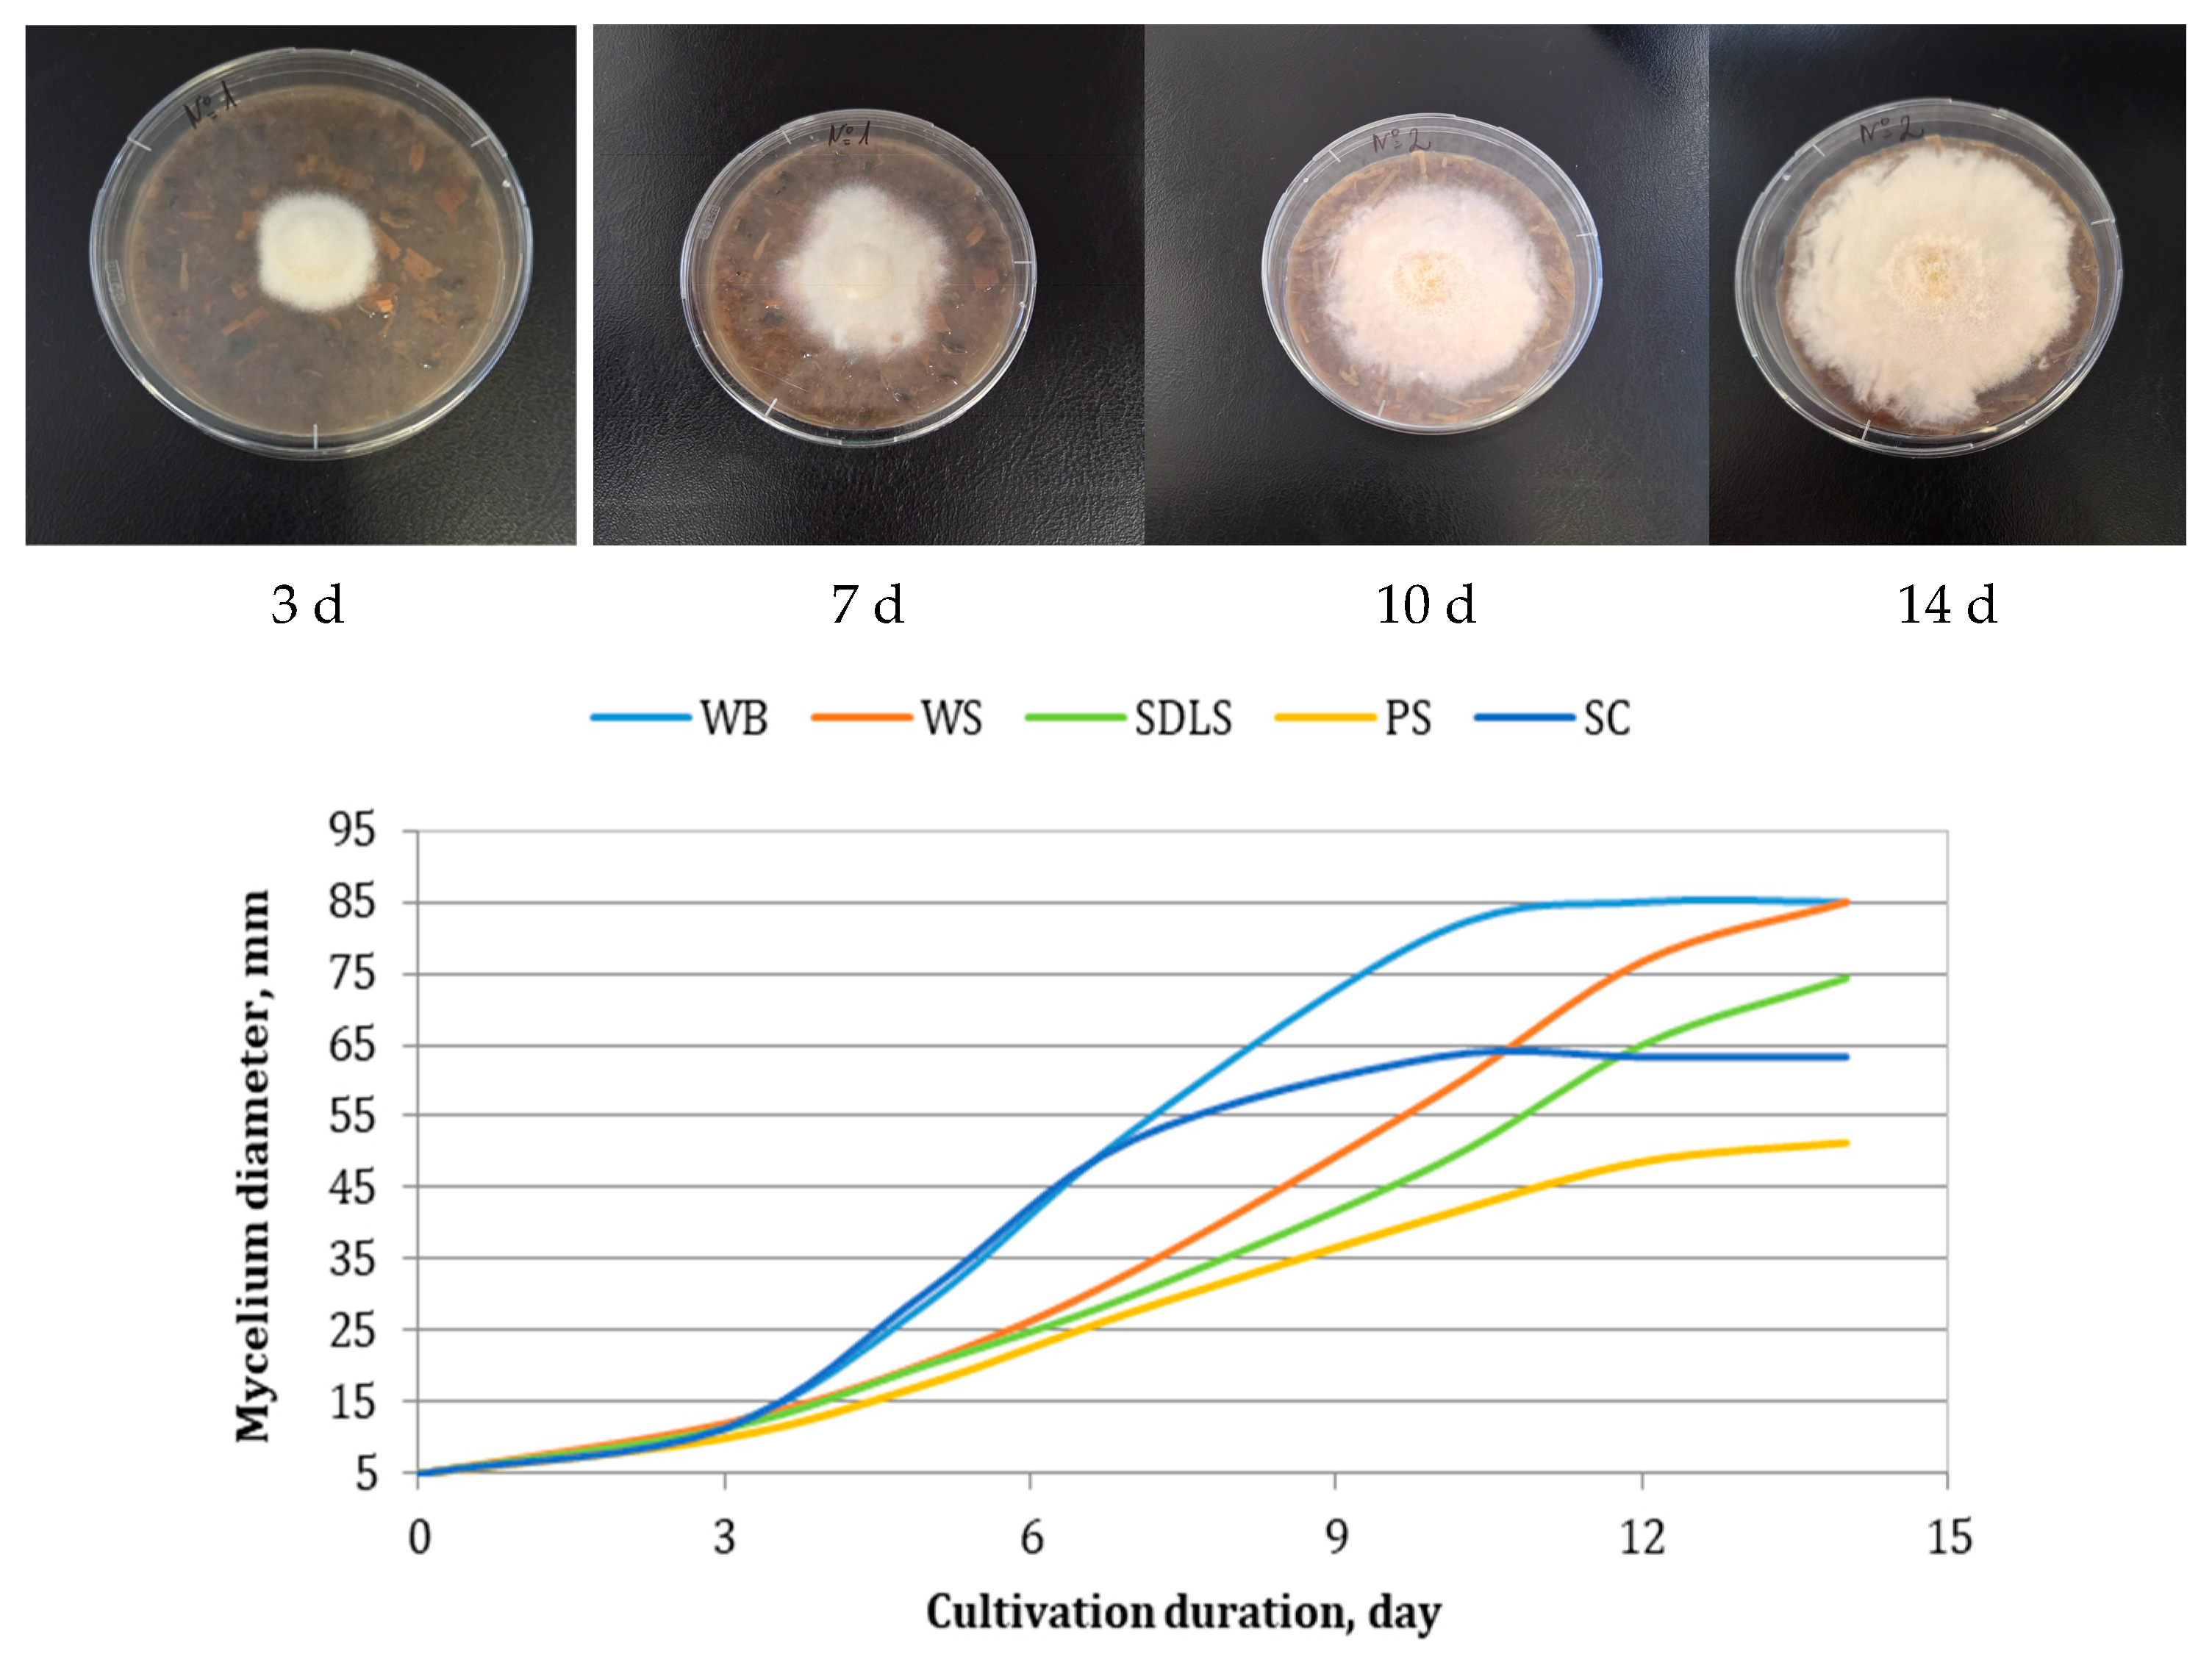

Agro-Industrial Residues as Cost-Effective and Sustainable Substrates for the Cultivation of Epicoccum nigrum, with Insights into Growth Kinetic Characteristics and Biological Activities
Abstract
1. Introduction
2. Materials and Methods
2.1. Fungal Strain
2.2. Agro-Industrial Substrates and Preparation Procedure
2.3. Proximate Composition Characterization of the Substrates
2.4. Cultivation and Modeling of the Kinetics of the Process
2.5. Solid-State Cultivation and Post-Cultivation Treatment
2.6. Determination of Enzyme Activities
2.6.1. Total Cellulolytic Activity (Filter Paper Assay, FPA)
2.6.2. Amylolytic Activities
2.6.3. Ligninolytic Activities
2.7. Determination of Antifungal Activities
2.7.1. In Vitro Antagonism Determination
2.7.2. Minimal Inhibitory Concentration (MIC) Determination
2.8. Statistical Analysis
3. Results and Discussion
3.1. Characterization of the Agro-Industrial Substrates
3.2. Cultivation of E. nigrum and Modeling of the Kinetics of the Process
3.3. Bioactivity
3.3.1. Determination of Enzyme Activities
3.3.2. Determination of Antifungal Activity
4. Conclusions
Supplementary Materials
Author Contributions
Funding
Institutional Review Board Statement
Informed Consent Statement
Data Availability Statement
Conflicts of Interest
Abbreviations
| SSC | solid-state cultivation |
| WS | wheat straw |
| PS | pine sawdust |
| WB | wheat bran |
| SC | sunflower cake |
| SDLS | steam-distilled lavender straw |
| GalA | anhydrouronic acid |
| TDF | total dietary fibers |
| IDF | insoluble dietary fibers |
| SDF | soluble dietary fibers |
| DE | degree of esterification |
| MIC | minimal inhibitory concentration |
| DMBA | 3,4-dimethoxybenzyl alcohol |
| FPA | filter paper assay |
| GLA | glucoamylase activity |
| AAA | α-amylase activity |
References
- Madeira, J.; Contesini, F.J.; Calzado, F.; Rubio, M.V.; Zubieta, M.P.; Lopes, D.B.; de Melo, R.R. Agro-industrial residues and microbial enzymes: An overview on the eco-friendly bioconversion into high value-added products. In Biotechnology of Microbial Enzymes; Brahmachari, G., Ed.; Elsevier: London, UK, 2017; pp. 475–511. [Google Scholar]
- Vučurović, D.; Bajić, B.; Trivunović, Z.; Dodić, J.; Zeljko, M.; Jevtić-Mučibabić, R.; Dodić, S. Biotechnological Utilization of Agro-Industrial Residues and By-Products—Sustainable Production of Biosurfactants. Foods 2024, 13, 711. [Google Scholar] [CrossRef]
- Kassim, F.O.; Thomas, C.L.P.; Afolabi, O.O.D. Integrated conversion technologies for sustainable agri-food waste valorization: A critical review. Biomass Bioenergy 2022, 156, 106314. [Google Scholar] [CrossRef]
- Shah, A.M.; Zhang, H.; Shahid, M.; Ghazal, H.; Shah, A.R.; Niaz, M.; Naz, T.; Ghimire, K.; Goswami, N.; Shi, W.; et al. The vital roles of agricultural crop residues and agro-industrial by-products to support sustainable livestock productivity in subtropical regions. Animals 2025, 15, 1184. [Google Scholar] [CrossRef] [PubMed]
- Pilafidis, S.; Diamantopoulou, P.; Gkatzionis, K.; Sarris, D. Valorization of agro-industrial wastes and residues through the production of bioactive compounds by macrofungi in liquid state cultures: Growing circular economy. Appl. Sci. 2022, 12, 11426. [Google Scholar] [CrossRef]
- Georganas, A.; Giamouri, E.; Pappas, A.C.; Papadomichelakis, G.; Galliou, F.; Manios, T.; Tsiplakou, E.; Fegeros, K.; Zervas, G. Bioactive compounds in food waste: A review on the transformation of food waste to animal feed. Foods 2020, 9, 291. [Google Scholar] [CrossRef]
- Sarsaiya, S.; Jain, A.; Kumar Awasthi, S.; Duan, Y.; Kumar Awasthi, M.; Shi, J. Microbial dynamics for lignocellulosic waste bioconversion and its importance with modern circular economy, challenges and future perspectives. Bioresour. Technol. 2019, 291, 121905. [Google Scholar] [CrossRef] [PubMed]
- Parfitt, J.; Barthel, M.; Macnaughton, S. Food waste within food supply chains: Quantification and potential for change to 2050. Philos. Trans. R. Soc. B Biol. Sci. 2010, 365, 3065–3081. [Google Scholar] [CrossRef]
- Ferronato, N.; Torretta, V. Waste mismanagement in developing countries: A review of global issues. Int. J. Environ. Res. Public Health 2019, 16, 1060. [Google Scholar] [CrossRef] [PubMed]
- Hamelin, L.; Borzęcka, M.; Kozak, M.; Pudełko, R. A spatial approach to bioeconomy: Quantifying the residual biomass potential in the EU-27. Renew. Sustain. Energy Rev. 2019, 100, 127–142. [Google Scholar] [CrossRef]
- Matei, E.; Râpă, M.; Predescu, A.M.; Țurcanu, A.A.; Vidu, R.; Predescu, C.; Bobirica, C.; Bobirica, L.; Orbeci, C. Valorization of agri-food wastes as sustainable eco-materials for wastewater treatment: Current state and new perspectives. Materials 2021, 14, 4581. [Google Scholar] [CrossRef]
- Azelee, N.I.W.; Manas, N.H.A.; Dailin, D.J.; Ramli, A.N.M.; Shaarani, S.M. Biological Treatment of Agro-Industrial Waste. In Valorisation of Agro-Industrial Residues—Volume I: Biological Approaches; Zakaria, Z., Boopathy, R., Dib, J., Eds.; Springer: Cham, Switzerland, 2020; pp. 59–80. [Google Scholar]
- Javourez, U.; O’Donohue, M.; Hamelin, L. Waste-to-nutrition: A review of current and emerging conversion pathways. Biotechnol. Adv. 2021, 53, 107857. [Google Scholar] [CrossRef]
- Foong, L.C.; Loh, C.W.L.; Ng, H.S.; Lan, J.C. Recent development in the production strategies of microbial carotenoids. World J. Microbiol. Biotechnol. 2021, 37, 12. [Google Scholar] [CrossRef]
- El-Sayed, E.R.; Gach, J.; Olejniczak, T.; Boratyński, F. A new endophyte Monascus ruber SRZ112 as an efficient production platform of natural pigments using agro-industrial wastes. Sci. Rep. 2022, 12, 12611. [Google Scholar] [CrossRef] [PubMed]
- Pelkmans, J.F.; Patil, M.B.; Gehrmann, T.; Reinders, M.J.; Wösten, H.A.; Lugones, L.G. Transcription factors of Schizophyllum commune involved in mushroom formation and modulation of vegetative growth. Sci. Rep. 2017, 7, 310. [Google Scholar] [CrossRef] [PubMed]
- Meyer, V.; Andersen, M.R.; Brakhage, A.A.; Braus, G.H.; Caddick, M.X.; Cairns, T.C.; de Vries, R.P.; Haarmann, T.; Hansen, K.; Hertz-Fowler, C.; et al. Current challenges of research on filamentous fungi in relation to human welfare and a sustainable bio-economy: A white paper. Fungal Biol. Biotechnol. 2016, 3, 6. [Google Scholar] [CrossRef] [PubMed]
- Meyer, V.; Basenko, E.Y.; Benz, J.P.; Braus, G.H.; Caddick, M.X.; Csukai, M.; de Vries, R.P.; Endy, D.; Frisvad, J.C.; Gunde-Cimerman, N.; et al. Growing a circular economy with fungal biotechnology: A white paper. Fungal Biol. Biotechnol. 2020, 7, 5. [Google Scholar] [CrossRef]
- Hashem, A.H.; Attia, M.S.; Kandil, E.K.; Fawzi, M.M.; Abdelrahman, A.S.; Khader, M.S.; Khodaira, M.A.; Emam, A.E.; Goma, M.A.; Abdelaziz, A.M. Bioactive compounds and biomedical applications of endophytic fungi: A recent review. Microb. Cell Factories 2023, 22, 107, Erratum in Microb. Cell Factories 2023, 22, 122. [Google Scholar] [CrossRef]
- Frisvad, J.C.; Andersen, B.; Thrane, U. The use of secondary metabolite profiling in chemotaxonomy of filamentous fungi. Mycol. Res. 2008, 112, 231–240. [Google Scholar] [CrossRef]
- Attia, M.S.; Salem, M.S.; Abdelaziz, A.M. Endophytic fungi Aspergillus spp. reduce fusarial wilt disease severity, enhance growth, metabolism and stimulate the plant defense system in pepper plants. Biomass Convers. Biorefin. 2024, 14, 16603–16613. [Google Scholar] [CrossRef]
- Zhang, P.; Yuan, X.-L.; Du, Y.-M.; Zhang, H.-B.; Shen, G.-M.; Zhang, Z.-F.; Liang, Y.-J.; Zhao, D.-L.; Xu, K. Angularly prenylated indole alkaloids with antimicrobial and insecticidal activities from an endophytic fungus Fusarium sambucinum TE-6L. J. Agric. Food Chem. 2019, 67, 11994–12001. [Google Scholar] [CrossRef]
- Manganyi, M.C.; Ateba, C.N. Untapped potentials of endophytic fungi: A review of novel bioactive compounds with biological applications. Microorganisms 2020, 8, 1934. [Google Scholar] [CrossRef] [PubMed]
- Hawas, U.W.; Abou El-Kassem, L.T. Anticancer and antiviral diketopiperazine produced by the Red Sea endophytic fungus Penicillium chrysogenum. Lett. Org. Chem. 2019, 16, 409–414. [Google Scholar] [CrossRef]
- Mastouri, F.; Björkman, T.; Harman, G.E. Seed treatment with Trichoderma harzianum alleviates biotic, abiotic, and physiological stresses in germinating seeds and seedlings. Phytopathology 2010, 100, 1213–1221. [Google Scholar] [CrossRef]
- Murphy, B.R.; Doohan, F.M.; Hodkinson, T.R. Yield increase induced by the fungal root endophyte Piriformospora indica in barley grown at low temperature is nutrient limited. Symbiosis 2014, 62, 29–39. [Google Scholar] [CrossRef]
- Taguiam, J.D.; Evallo, E.; Balendres, M.A. Epicoccum species: Ubiquitous plant pathogens and effective biological control agents. Eur. J. Plant Pathol. 2021, 159, 713–725. [Google Scholar] [CrossRef]
- Kou, Z.-A.; Zhang, Z.-K.; Zhang, W.-X.; Wang, X.-F.; Liu, L.; Teng, G.-X.; Tian, Y.-Q. First report of Epicoccum nigrum causing leaf spot of endive (Cichorium endivia L.) in China. Crop Prot. 2024, 177, 106534. [Google Scholar] [CrossRef]
- Fávaro, L.C.; Sebastianes, F.L.; Araújo, W.L. Epicoccum nigrum P16, a sugarcane endophyte, produces antifungal compounds and induces root growth. PLoS ONE 2012, 7, e36826. [Google Scholar] [CrossRef]
- Elnaggar, M.S.; Fayez, S.; Anwar, A.; Ebada, S.S. Cytotoxic naphtho- and benzofurans from an endophytic fungus Epicoccum nigrum Ann-B-2 associated with Annona squamosa fruits. Sci. Rep. 2024, 14, 4940. [Google Scholar] [CrossRef]
- Li, T.; Im, J.; Lee, J. Genetic Diversity of Epicoccum nigrum and its effects on Fusarium graminearum. Mycobiology 2022, 50, 457–466. [Google Scholar] [CrossRef]
- Musetti, R.; Grisan, S.; Polizzotto, R.; Martini, M.; Paduano, C.; Osler, R. Interactions between ‘Candidatus Phytoplasma mali’ and the apple endophyte Epicoccum nigrum in Catharanthus roseus plants. J. Appl. Microbiol. 2011, 110, 746–756. [Google Scholar] [CrossRef] [PubMed]
- Sawinder, K.; Panesar, P.S.; Gurumayum, S.; Singh, J.; Assouguem, A.; Lazraq, A.; Ullah, R.; Ali, E.A.; Skender, A.; Rasane, P. Stability kinetics of orevactaene pigments produced by Epicoccum nigrum in solid-state fermentation. Open Chem. 2023, 21, 20230166. [Google Scholar] [CrossRef]
- El-Sayed, E.R.; Ahmed, A.S.; Al-Hagar, O.E.A. Agro-industrial wastes for production of paclitaxel by irradiated Aspergillus fumigatus under solid-state fermentation. J. Appl. Microbiol. 2020, 128, 1427–1439. [Google Scholar] [CrossRef]
- Manan, M.A.; Webb, C. Design aspects of solid-state fermentation as applied to microbial bioprocessing. J. Appl. Biotechnol. Bioeng. 2017, 4, 511–532. [Google Scholar] [CrossRef]
- Zaki, A.G.; El-Sayed, E.R. New and potent production platform of the acetylcholinesterase inhibitor Huperzine A by gammairradiated Alternaria brassicae under solid-state fermentation. Appl. Microbiol. Biotechnol. 2021, 105, 8869–8880. [Google Scholar] [CrossRef]
- Baldzhieva, R.; Brazkova, M.; Blazheva, D.; Goranov, B.; Stefanova, P.; Ganeva, Z.; Teneva, D.; Denev, P.; Angelova, G. Growth kinetics modeling and evaluation of antiphytopathogenic activity of newly isolated fungicolous Epicoccum nigrum associated with Dryad’s Saddle (Polyporaceae). Agriculture 2024, 14, 2179. [Google Scholar] [CrossRef]
- Ali, S.A.-B.; Abdelmoaty, H.; Ramadan, H.; Salman, Y. The endophytic fungus Epicoccum nigrum: Isolation, molecular identification and study its antifungal activity against phytopathogenic fungus Fusarium solani. J. Microbiol. Biotechnol. Food Sci. 2024, 13, e10093. [Google Scholar] [CrossRef]
- Lee, A.J.; Cadelis, M.M.; Kim, S.H.; Swift, S.; Copp, B.R.; Villas-Boas, S.G. Epipyrone A, a broad-spectrum antifungal compound produced by Epicoccum nigrum ICMP 19927. Molecules 2020, 25, 5997. [Google Scholar] [CrossRef] [PubMed]
- Dzoyem, J.P.; Melong, R.; Tsamo, A.T.; Maffo, T.; Kapche, D.G.W.F.; Ngadjui, B.T.; McGaw, L.J.; Eloff, J.N. Cytotoxicity, antioxidant and antibacterial activity of four compounds produced by an endophytic fungus Epicoccum nigrum associated with Entada abyssinica. Rev. Bras. Farmacogn. 2017, 27, 251–253. [Google Scholar] [CrossRef]
- Nzabanita, C.; Zhang, L.; Zhao, H.; Wang, Y.; Wang, Y.; Sun, M.; Wang, S.; Guo, L. Fungal endophyte Epicoccum nigrum 38L1 inhibits in vitro and in vivo the pathogenic fungus Fusarium graminearum. Biol. Control 2022, 174, 105010. [Google Scholar] [CrossRef]
- Carboué, Q.; Besaury, L.; Petracco, E.; Fournier, R.; Dosso, A.; Godon, B.; Sayagh, C.; Martinez, A.; Legin, E.; Alavoine, G.; et al. Pigments production from a newly isolated psychrotrophic strain of Epicoccum nigrum grown on non-sterile exhausted sugar beet pulp through solid state fermentation. Chem. Eng. J. 2025, 507, 160682. [Google Scholar] [CrossRef]
- Angelova, G.; Yemendzhiev, H.; Zaharieva, R.; Brazkova, M.; Koleva, R.; Stefanova, P.; Baldzhieva, R.; Vladev, V.; Krastanov, A. Mycelium-Based Composites Derived from Lignocellulosic Residual By-Products: An Insight into Their Physico-Mechanical Properties and Biodegradation Profile. Appl. Sci. 2025, 15, 6333. [Google Scholar] [CrossRef]
- Blumenkrantz, N.; Asboe-Hansen, G. New method for quantitative determination of uronic acids. Anal. Biochem. 1973, 54, 484–489. [Google Scholar] [CrossRef]
- Marovska, G.I.; Hambarliyska, I.P.; Petkova, N.T.; Ivanov, I.G.; Georgiev, V.; Topuzova, M.G.; Slavov, A.M. General characteristics of lavender biomass (Lavandula angustifolia Mill.) before and after industrial distillation. Food Sci. Appl. Biotechnol. 2024, 7, 133–144. [Google Scholar] [CrossRef]
- AOAC. Official Method 991.43. Total, Soluble, and Insoluble Dietary Fiber in Foods, En-Zymatic-Gravimetric Method, MES-TRIS Buffer; Association of Official Analytical Chemists International: Gaithersburg, MD, USA, 1994. [Google Scholar]
- de Escalada Pla, M.F.; González, P.; Sette, P.; Portillo, F.; Rojas, A.M.; Gerschenson, L.N. Effect of processing on physico-chemical characteristics of dietary fibre concentrates obtained from peach (Prunus persica L.) peel and pulp. Food Res. Int. 2012, 49, 184–192. [Google Scholar] [CrossRef]
- Bouguettoucha, A.; Balannec, B.; Amrane, A. Unstructured models for lactic acid fermentation—A review. Food Technol. Biotechnol. 2011, 49, 3–12. [Google Scholar]
- Ibarz, A.; Augusto, P.E.D. An autocatalytic kinetic model for describing microbial growth during fermentation. Bioprocess Biosyst. Eng. 2015, 38, 199–205. [Google Scholar] [CrossRef]
- Gaponov, K.P. Processes and Apparatus for Microbiological Industry; Legkaya I Pishchevaya Promyshlenmost: Moscow, Russia, 1981; p. 240. (In Russian) [Google Scholar]
- Kemmer, G.; Keller, S. Nonlinear least-squares data fitting in Excel spreadsheets. Nat. Protoc. 2010, 5, 267–281. [Google Scholar] [CrossRef]
- Choi, M.; Al-Zahrani, S.M.; Lee, S.Y. Kinetic model-based feed-forward controlled fed-batch fermentation of Lactobacillus rhamnosus for the production of lactic acid from Arabic date juice. Bioprocess Biosyst. Eng. 2014, 37, 1007–1015. [Google Scholar] [CrossRef]
- Granato, D.; Calado, V.; Pinto, E.R. Optimization of food processes using mixture experiments. In Mathematical and Statistical Applications in Food Engineering, 1st ed.; Sevdav, S., Singh, A., Eds.; CRC Press: Boca Raton, FL, USA, 2020; p. 15. [Google Scholar] [CrossRef]
- NIST/SEMATECH e-Handbook of Statistical Methods; National Institute of Standards and Technology: Gaithersburg, MD, USA, 2012. Available online: https://www.itl.nist.gov/div898/handbook/ (accessed on 22 August 2025). [CrossRef]
- Lever, M. A New Reaction for Colorimetric Determination of Carbohydrates. Anal. Biochem. 1972, 47, 273–279. [Google Scholar] [CrossRef]
- Fuwa, H. A new method of microdetermination of amylase activity by the use of amylase as the substrate. J. Biochem. 1954, 41, 583–603. [Google Scholar] [CrossRef]
- Ride, J.P. The effect of induced lignification on the resistance of wheat cell walls to fungal degradation. Physiol. Plant Pathol. 1970, 16, 187–196. [Google Scholar] [CrossRef]
- Wariishi, H.; Dunford, H.B.; McDonald, I.D.; Gold, M.H. Manganese Peroxidase from the lignin-degrading Basidiomycette Phanerochaete chrysosporium. J. Biol. Chem. 1989, 264, 3335–3340. [Google Scholar] [CrossRef]
- Tien, M.; Kirk, T.K. Lignin-Degrading Enzyme from the Hymenomycete Phanerochaete chrysosporium. Burds Sci. 1983, 221, 661–663. [Google Scholar] [CrossRef]
- CLSI. Method for Broth Dilution Antifungal Susceptibility Testing of Filamentous Fungi, Approved Standard, 2nd ed.; CLSI document M38-A2; Clinical and Laboratory Standards Institute: Wayne, PA, USA, 2008. [Google Scholar]
- Vasudha, C.; Sarla, L. Nutritional quality analysis of sunflower seed cake (SSC). Pharma Innov. J. 2021, 10, 720–728. [Google Scholar]
- Ogórek, R.; Przywara, K.; Piecuch, A.; Cal, M.; Lejman, A.; Matkowski, K. Plant-fungal interactions: A case study of Epicoccoum nigrum Link. Plants 2020, 9, 1691. [Google Scholar] [CrossRef] [PubMed]
- Brown, A.E. Epicoccum nigrum, a primary saprophyte involved in the retting of flax. Trans. Br. Mycol. Soc. 1984, 83, 29–35. [Google Scholar] [CrossRef]
- Martim, D.B.; dos Santos, F.C.; Barbosa-Tessmann, I.P. Production, partial purification, and characterization of a glucoamylase from Epicoccum nigrum. Acta Scientiarum. Biol. Sci. 2023, 45, e61179. [Google Scholar] [CrossRef]
- Xu, X.; Li, J.; Yang, X.; Zhang, L.; Wang, S.; Shen, G.; Hui, B.; Xiao, J.; Zhou, C.; Wang, X.; et al. Epicoccum spp. causing maize leaf spot in Heilongjiang Province, China. Plant Dis. 2022, 106, 3050–3060. [Google Scholar] [CrossRef] [PubMed]
- Zhang, J.; Cui, J.H.; Yin, T.; Sun, L.; Li, G. Activated effect of lignin on α-amylase. Food Chem. 2013, 141, 2229–2237. [Google Scholar] [CrossRef]
- Soccol, C.R.; Rojan, P.J.; Patel, A.K.; Woiciechowski, A.L.; Vandenberghe, L.P.; Pandey, A. Glucoamylase. In Enzyme Technology; Pandey, A., Webb, C., Soccol, R.C., Larroche, C., Eds.; Asiatech Publishers, Inc.: New Delhi, India, 2006; pp. 221–237. [Google Scholar]
- De Paula, N.M.; da Silva, K.; Brugnari, T.; Haminiuk, C.W.I.; Maciel, G.M. Biotechnological potential of fungi from a mangrove ecosystem: Enzymes, salt tolerance and decolorization of a real textile effluent. Microbiol. Res. 2022, 254, 126899. [Google Scholar] [CrossRef]
- Hoyte, S.M.; Elmer, P.A.G.; Parry, F.J.; Taylor, J.T.; Marsden, R.S. Biological suppression of Sclerotinia sclerotiorum in kiwifruit. Acta Hortic. 2007, 753, 661–668. [Google Scholar] [CrossRef]
- Huang, H.C.; Bremer, E.; Hynes, R.K.; Erickson, R.S. Foliar application of fungal biocontrol agents for the control of white mold of dry bean caused by Sclerotinia sclerotiorum. Biol. Control 2000, 18, 270–276. [Google Scholar] [CrossRef]
- Elkot, G.A.E.; Derbalah, A.S.H. Use of cultural filtrates of certain microbial isolates for powdery mildew control in squash. J. Plant Prot. Res. 2011, 51, 252–260. [Google Scholar] [CrossRef]
- Alcock, A.; Elmer, P.; Marsden, R.; Parry, F. Inhibition of Botrytis cinerea by epirodin: A secondary metabolite from New Zealand isolates of Epicoccum nigrum. J. Phytopathol. 2015, 163, 841–852. [Google Scholar] [CrossRef]
- Ogórek, R.; Plaskowska, E. Epicoccum nigrum for biocontrol agents in vitro of plant fungal pathogens. Commun. Agric. Appl. Biol. Sci. 2011, 76, 691–697. [Google Scholar]
- Park, J.Y.; Okada, G.; Takahashi, M.; Oyaizu, H. Screening of fungal antagonists against yellows of cabbage caused by Fusarium oxysporum f. sp. conglutinans. Mycoscience 2002, 43, 447–451. [Google Scholar] [CrossRef]
- Perelló, A.; Simón, M.R.; Arambarri, A.M.; Cordo, C.A. Greenhouse screening of the saprophytic resident microflora for control of leaf spots of wheat (Triticum aestivum). Phytoparasitica 2001, 29, 341–351. [Google Scholar] [CrossRef]
- Talontsi, F.M.; Dittrich, B.; Schüffler, A.; Sun, H.; Laatsch, H. Epicoccolides: Antimicrobial and antifungal polyketides from an endophytic fungus Epicoccum sp. associated with Theobroma cacao. Eur. J. Org. Chem. 2013, 15, 3174–3180. [Google Scholar] [CrossRef]
- Qader, M.M.; Hamed, A.A.; Soldatou, S.; Abdelraof, M.; Elawady, M.E.; Hassane, A.S.I.; Belbahri, L.; Ebel, R.; Rateb, M.E. Antimicrobial and antibiofilm activities of the fungal metabolites isolated from the marine endophytes Epicoccum nigrum M13 and Alternaria alternata 13A. Mar. Drugs 2021, 19, 232. [Google Scholar] [CrossRef] [PubMed]
- Badali, H.; Cañete-Gibas, C.; McCarthy, D.; Patterson, H.; Sanders, C.; David, M.P.; Mele, J.; Fan, H.; Wiederhold, N.P. Epidemiology and antifungal susceptibilities of mucoralean fungi in clinical samples from the United States. J. Clin. Microbiol. 2021, 59, JCM0123021. [Google Scholar] [CrossRef]
- Guevara-Suarez, M.; Sutton, D.A.; Cano-Lira, J.F.; García, D.; Martin-Vicente, A.; Wiederhold, N.; Guarro, J.; Gené, J. Identification and antifungal susceptibility of penicillium-like fungi from clinical samples in the United States. J. Clin. Microbiol. 2016, 54, 2155–2161. [Google Scholar] [CrossRef] [PubMed]
- Gonçalves, S.S.; Stchigel, A.M.; Cano, J.; Guarro, J.; Colombo, A.L. In vitro antifungal susceptibility of clinically relevant species belonging to Aspergillus section Flavi. Antimicrob. Agents Chemother. 2013, 57, 1944–1947. [Google Scholar] [CrossRef] [PubMed]
- Xu, K.; Wei, X.-L.; Xue, L.; Zhang, Z.-F.; Zhang, P. Antimicrobial meroterpenoids and erythritol derivatives isolated from the marine-algal-derived endophytic fungus Penicillium chrysogenum XNM-12. Mar. Drugs 2020, 18, 578. [Google Scholar] [CrossRef] [PubMed]

| Component | Content, g/100 g DW | |||||||
|---|---|---|---|---|---|---|---|---|
| PS | SUM | WB | SUM | SC | SUM | WS | SUM | |
| TDF | 98.10 ± 0.41 a | - | 61.64 ± 0.24 c | - | 46.81 ± 0.73 d | - | 91.21 ± 0.71 b | - |
| IDF | 97.80 ± 0.41 a | - | 55.32 ± 0.18 c | - | 43.45 ± 0.73 d | - | 89.75 ± 0.71 b | - |
| SDF | 0.30 ± 0.04 d | - | 6.32 ± 0.24 a | - | 3.36 ± 0.34 b | - | 1.46 ± 0.01 c | - |
| Polyuronides | 11.00 ± 0.60 d | - | 26.00 ± 0.25 a | - | 20.10 ± 0.21 b | - | 13.00 ± 0.50 c | - |
| DE | 80.00 ± 1.24 a | - | 26.81 ± 1.32 c | - | 42.60 ± 1.47 b | - | 83.01 ± 1.69 a | - |
| GalA | 0.55 ± 0.07 d | 97.53 ± 1.21 b | 2.14 ± 0.12 a | 85.49 ± 1.33 d | 1.72 ± 0.11 b | 94.57 ± 1.67 c | 1.01 ± 0.08 c | 98.41 ± 1.39 a |
| NCP | 4.32 ± 0.21 c | 15.80 ± 0.15 a | 5.13 ± 0.34 b | 5.67 ± 0.28 b | ||||
| Cellulose | 66.69 ± 0.66 a | 39.49 ± 0.59 d | 42.66 ± 0.56 c | 61.81 ± 0.68 b | ||||
| Lignin | 25.97 ± 0.49 d | 28.06 ± 0.28 c | 45.06 ± 0.38 a | 29.92 ± 0.45 b | ||||
| Nutrient Medium | Logistic Curve Model | Reversible Autocatalytic Growth Model | |||||
|---|---|---|---|---|---|---|---|
| µmax, d−1 | δ, mm.d−1 | R2 | k1, d−1 | S0′, mm | K/1 + K | R2 | |
| WB | 0.523 ± 0.029 a | 0.0062 ± 0.0003 ab | 0.9965 | 0.0038 ± 0.0000 a | 99 ± 0 a | 0.9516 ± 0.0022 a | 0.9912 |
| WS | 0.439 ± 0.015 ab | 0.0052 ± 0.0002 a | 0.9981 | 0.0037 ± 0.0000 a | 100 ± 0 a | 0.8849 ± 0.0178 a | 0.9950 |
| SDLS | 0.421 ± 0.017 bc | 0.0056 ± 0.0002 ab | 0.9833 | 0.0041 ± 0.0006 a | 81 ± 1 b | 0.7907 ± 0.1650 ab | 0.9983 |
| PS | 0.375 ± 0.005 c | 0.0080 ± 0.0007 c | 0.9829 | 0.0036 ± 0.0002 a | 79 ± 1 c | 0.7727 ± 0.0123 b | 0.9851 |
| SC | 0.438 ± 0.085 abc | 0.0067 ± 0.0008 bc | 0.9935 | 0.0039 ± 0.0001 a | 98 ± 0 a | 0.6932 ± 0.0717 ab | 0.9868 |
| Factor | Low | High | Optimum |
|---|---|---|---|
| WB | 0.0 | 1.0 | 0.588 |
| WS | 0.0 | 1.0 | 0.065 |
| SDLS | 0.0 | 1.0 | 0.193 |
| PS | 0.0 | 1.0 | 0.154 |
| Logistic Curve Model | Reversible Autocatalytic Growth Model | |||||
|---|---|---|---|---|---|---|
| µmax, d−1 | δ, mm.d−1 | R2 | k1, d−1 | S0′, mm | K/1 + K | R2 |
| 0.325 ± 0.028 | 0.0034 ± 0.0004 | 0.9848 | 0.0034 ± 0.0001 | 90 ± 1 | 0.9851 ± 0.0166 | 0.9887 |
| Test Microorganism | MIC, mg/mL | ||
|---|---|---|---|
| WB | WS | Optimized Medium | |
| Alternaria sp. | 0.625 | 0.313 | 0.625 |
| Alternaria alternata | 1.25 | 1.25 | 1.25 |
| Aspergillus flavus | 2.5 | 0.313 | 1.25 |
| Botrytis cinerea | 0.625 | 0.313 | 0.625 |
| Fusarium verticillioides | 0.625 | 0.625 | 0.625 |
| Fusarium oxysporum | 1.25 | 0.625 | 1.25 |
| Mucor sp. | 1.25 | 0.625 | 1.25 |
| Penicillium sp. | 1.25 | 0.156 | 1.25 |
| Sclerotinia sclerotiorum | 0.313 | 0.313 | 0.156 |
Disclaimer/Publisher’s Note: The statements, opinions and data contained in all publications are solely those of the individual author(s) and contributor(s) and not of MDPI and/or the editor(s). MDPI and/or the editor(s) disclaim responsibility for any injury to people or property resulting from any ideas, methods, instructions or products referred to in the content. |
© 2025 by the authors. Licensee MDPI, Basel, Switzerland. This article is an open access article distributed under the terms and conditions of the Creative Commons Attribution (CC BY) license (https://creativecommons.org/licenses/by/4.0/).
Share and Cite
Ganeva, Z.; Goranov, B.; Brazkova, M.; Blazheva, D.; Baldzhieva, R.; Stefanova, P.; Slavov, A.; Denkova-Kostova, R.; Bozhkov, S.; Angelova, G. Agro-Industrial Residues as Cost-Effective and Sustainable Substrates for the Cultivation of Epicoccum nigrum, with Insights into Growth Kinetic Characteristics and Biological Activities. Appl. Sci. 2025, 15, 10571. https://doi.org/10.3390/app151910571
Ganeva Z, Goranov B, Brazkova M, Blazheva D, Baldzhieva R, Stefanova P, Slavov A, Denkova-Kostova R, Bozhkov S, Angelova G. Agro-Industrial Residues as Cost-Effective and Sustainable Substrates for the Cultivation of Epicoccum nigrum, with Insights into Growth Kinetic Characteristics and Biological Activities. Applied Sciences. 2025; 15(19):10571. https://doi.org/10.3390/app151910571
Chicago/Turabian StyleGaneva, Zlatka, Bogdan Goranov, Mariya Brazkova, Denica Blazheva, Radka Baldzhieva, Petya Stefanova, Anton Slavov, Rositsa Denkova-Kostova, Stefan Bozhkov, and Galena Angelova. 2025. "Agro-Industrial Residues as Cost-Effective and Sustainable Substrates for the Cultivation of Epicoccum nigrum, with Insights into Growth Kinetic Characteristics and Biological Activities" Applied Sciences 15, no. 19: 10571. https://doi.org/10.3390/app151910571
APA StyleGaneva, Z., Goranov, B., Brazkova, M., Blazheva, D., Baldzhieva, R., Stefanova, P., Slavov, A., Denkova-Kostova, R., Bozhkov, S., & Angelova, G. (2025). Agro-Industrial Residues as Cost-Effective and Sustainable Substrates for the Cultivation of Epicoccum nigrum, with Insights into Growth Kinetic Characteristics and Biological Activities. Applied Sciences, 15(19), 10571. https://doi.org/10.3390/app151910571

